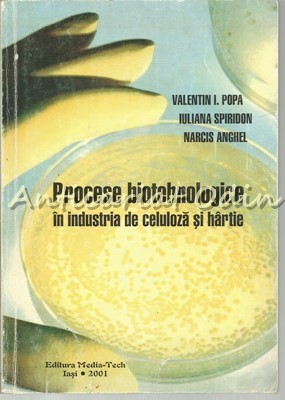

Procese Biotehnologice In Industria De Celuloza Si Hartie - Valentin I. Popa
- Ramburs
-
Ramburs cu Garantia de Livrare

Curierul special îți livrează produsul pe care tu îl achiți la primire. Dacă produsul nu este ca în descriere, îți recuperezi banii, inclusiv taxele de transport.
- Online


Descriere
Raporteaza produsVânzatorul este direct răspunzator pentru produsul afișat în această pagină.
Specificatii
Titlu: Procese Biotehnologice In Industria De Celuloza Si Hartie - Valentin I. Popa
Autor(i): Valentin I. Popa, Iuliana Spiridon, Narcis Anghel
Volum:
Editura: Media-Tech
Oraș: Iasi
An: 2001
Număr pagini: 237
Limba: Romana
Copertă: Brosata
ISBN: 973-85088-8-6
Dimensiuni (cm): 16,5*23,5*1
Stare: Buna
Galerie foto

Modalitati de livrare si plata
LIVRARE
In Iasi
-
- Prin curier cu Garantia de Livrare - 18 Lei in max. 4 zile lucratoare

In Romania:
-
- Prin curier cu Garantia de Livrare - 18 Lei in max. 4 zile lucratoare

- Ridicare de la locker Miercuri, 8 Oct. - 13,09 Lei
PLATA
- - Ramburs
- - Ramburs cu Garantia de Livrare

Curierul special îți livrează produsul pe care tu îl achiți la primire. Dacă produsul nu este ca în descriere, îți recuperezi banii, inclusiv taxele de transport.
- - Online
Politica de retur
- - Produsul se poate returna in maxim 3 zile lucratoare
- - Metoda de retur: Ramburs contravaloare produs
- - Costul transportului va fi suportat de catre cumparator
- - Alte detalii: Retur acceptat in conditiile Garantiei de Livrare
Spune-ti parerea acordand o nota produsului